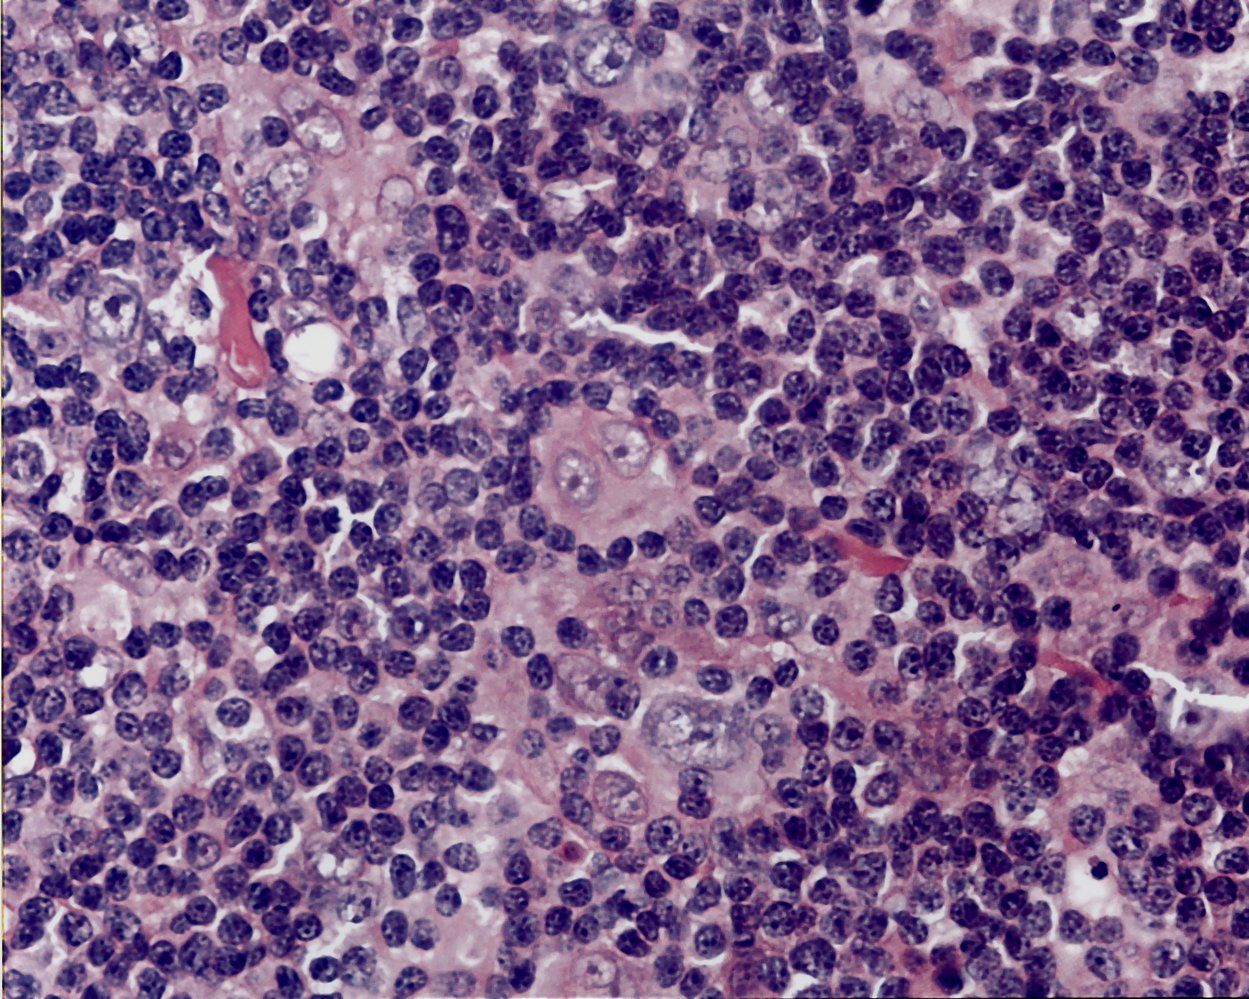

A 27-year-old man comes to the physician for a follow-up evaluation. Two days ago, he was involved in a physical altercation and sustained a bruise on his left arm and an injury to his left shoulder. Initially, there was a reddish-purple discoloration on his left upper arm. A photograph of the left upper arm today is shown. Which of the following enzymes is most likely responsible for the observed changes in color?

(a) Aminolevulinate dehydratase
(b) Bilirubin UDP-glucuronosyltransferase
(c) Porphobilinogen deaminase
(d) Heme oxygenase
(e) Uroporphyrinogen decarboxylase
(d) Heme oxygenase
Trauma --> Hgb released from RBCs --> purple/black bruise due to coagulation + degradation into bile pigment --> dark green due to conversion of heme into biliverden by heme oxygenase. Biliverden reductase converts into the yellow bilirubin (yellow bruise).
A 26-year-old man comes to the physician for episodic fever, recurrent night sweats, and a 6-kg (14.2-lb) weight loss over the past 2 months. He reports that the fever lasts for 7 to 10 days, then subsides completely for about a week before returning again. His temperature is 39°C (102.2°F). Physical examination shows nontender cervical and supraclavicular lymphadenopathy. An x-ray of the chest shows bilateral mediastinal masses. Resection of a cervical lymph node is performed. A photomicrograph of the resected specimen is shown. Further histopathological examination is most likely to show which of the following findings?
(a) Cells staining + for tartrate-resistant acid phosphatase.
(b) Cells staining + for CD15, CD30.
(c) Cells with BCR-ABL rearrangement.
(d) Cells overexpressing Bcl-2.
(e) Cells with t(8;14) chromosomal translocation.
(b) Cells staining + for CD15, CD30.
Reed-Sternberg cells, B-symptoms. Hodgkin lymphoma.
An otherwise healthy 23-year-old man comes to the physician because of a 3-day history of mild persistent bleeding from the site of a tooth extraction. He has no prior history of medical procedures or surgeries and no history of easy bruising. He appears well. Vital signs are within normal limits. Laboratory studies show:
Hemoglobin 12.4 g/dL (unremark)
Platelets 200,000/mm3 (unremark)
Prothrombin time 25 seconds (elevated)
Partial thromboplastin time (activated) 35 seconds (unremark)
Deficiency of which of the following coagulation factors is the most likely cause of this patient’s condition?
(a) Factor VII
(b) Factor V
(c) Factor II
(d) Factor VIII
(e) Factor X
(a) Factor VII.
Extrinsic pathway is deficient.
TIP: Prothrombin = "PT." When you think of PT, you think of "EX"ercise (~EXtrinsic pathway).
A 6-year-old girl is brought to the emergency department because of worsening confusion over the past 2 hours. She has had fever, productive cough, fatigue, and malaise for the past 2 days. She has not seen a physician in approximately 3 years. She appears lethargic. Her temperature is 38.9°C (102°F), pulse is 133/min, respirations are 33/min, and blood pressure is 86/48 mm Hg. Mucous membranes are dry. Pulmonary examination shows subcostal retractions and coarse crackles bilaterally. Her hemoglobin concentration is 8.4 g/dL and her leukocyte count is 16,000/mm3. A peripheral blood smear shows sickled red blood cells. Which of the following pathogens is the most likely cause of this patient's current condition?
(a) Salmonella paratyphi.
(b) Streptococcus pneumoniae.
(c) Neisseria meningitidis.
(d) Staphylococcus aureus.
(e) Nontypeable Haemophilus influenzae.
(b) Streptococcus pneumoniae.
Encapsulated bugs (Strep pneumo, N. meningitidis, H. flu type B/Hib) rely on opsonization for clearance. The spleen is a large source of that, and SCD patients often have functional asplenia. Pt has pneumonia.
Prophylaxis?
A 53-year-old woman with rheumatoid arthritis comes to the physician for a follow-up examination one week after being discharged from the hospital. While she was in the hospital, she received acetaminophen and erythropoietin. This patient most likely has which of the following additional conditions?
(a) Factor VIII deficiency.
(b) Vitamin K deficiency.
(c) Agranulocytosis.
(d) Anemia of chronic disease.
(e) Immune thrombocytopenic purpura.
(d) Anemia of chronic disease.
High doses of exogenous EPO can overcome the endogenous resistance to EPO.
An investigator is studying the effects of tissue hypoxia on skeletal muscles. Skeletal muscle hypoxia is induced by decreasing oxygen delivery to peripheral tissues. Which of the following is most likely to achieve this desired effect?
(a) Decrease serum [2,3-bisphosphoglycerate]
(b) Increase serum [H+]
(c) Decrease proportion of fetal Hgb
(d) Increase PaCO2
(e) Increase serum temperature
(a) Decrease serum [2,3-bisphosphoglycerate].
In order to induce skeletal muscle (peripheral tissue) hypoxia, you would need to induce a left-shift on the Hgb dissociation curve (which increases Hgb's affinity to O2).
Factors that do this: Decreased 2,3-BPG; decrease PaCO2; decreased body temp; increased pH.
A 14-year-old boy is brought to the emergency department because of a 2-day history of fatigue. He reports that during this time he has had occasional palpitations and shortness of breath. He has sickle cell disease. Current medications include hydroxyurea and folic acid. He appears fatigued. His temperature is 38.3°C (100.9°F), pulse is 120/min, respirations are 24/min, and blood pressure is 112/74 mm Hg. Examination shows pale conjunctivae. Cardiac examination shows a midsystolic ejection murmur. Laboratory studies show:
Hemoglobin 6.4 g/dL
Leukocyte count 6,000/mm3
Platelet count 168,000/mm3
Mean corpuscular volume 84 μm3
Reticulocyte count 0.1%
Which of the following is the most likely underlying cause of these findings?
(a) Parvovirus B19.
(b) Medication-induced hemolysis.
(c) Defect in erythrocyte membrane proteins.
(d) Splenic vaso-occlusion.
(e) Hemolytic crisis.
(a) Parvovirus B19.
Virus causes drop in erythropoiesis. In patients with underlying anemia (e.g. SCD), can lead to transient aplastic crisis.
A healthy 29-year-old woman comes to the doctor because of recurrent episodes of bleeding from the nose and gums during the past week. These episodes occur spontaneously and resolve with compression. She also had 1 episode of blood in the urine 2 days ago. Examination shows punctate, nonblanching, reddish macules over the neck, chest, and lower extremities. Her leukocyte count is 8600/mm3, hemoglobin concentration is 12.9 g/dL, and platelet count is 26500/mm3. A peripheral blood smear shows a reduced number of platelets with normal morphology. Evaluation of a bone marrow biopsy in this patient is most likely to show which of the following findings?
(a) Erythroid hyperplasia.
(b) Ringed sideroblasts.
(c) Absence of hematopoietic cells.
(d) Megakaryocyte hyperplasia.
(e) Plasma cell hyperplasia.
(d) Megakaryocyte hyperplasia.
Immune thrombocytopenia. Antibodies circulating peripherally target GpIIb/IIIa receptor. Bone marrow increases central proliferation (megakaryocytes = progenitors of platelets).
A 7-year-old boy is brought to the physician because of a 3-week history of burning sensation in his mouth. One year ago, a peripheral blood smear performed during workup of fatigue revealed erythrocytes without central pallor. His father had gallstones, for which he underwent cholecystectomy at the age of 26 years. Examination shows pallor of the mucosal membranes, mild scleral icterus, a swollen, red tongue, and several mouth ulcers. There is darkening of the skin over the dorsal surfaces of the fingers, toes, and creases of the palms and soles. His spleen is enlarged and palpable 3 cm below the left costal margin. Laboratory studies show a hemoglobin concentration of 9.1 g/dL, mean corpuscular volume of 104 μm3, and a reticulocyte count of 0.3%. Which of the following would most likely have prevented this patient's oropharyngeal symptoms?
(a) Cholecystectomy.
(b) Pneumococcal vaccine + antibiotic prophylaxis.
(c) RBC transfusions.
(d) Gluten-free diet.
(e) Vitamin B12 injections.
(f) Folic acid supplementation.
(f) Folic acid supplementation.
Hereditary spherocytosis.
A 64-year-old woman comes to the physician because of a 7-month history of abdominal discomfort, fatigue, and a 6.8-kg (15-lb) weight loss. Physical examination shows generalized pallor and splenomegaly. Laboratory studies show anemia with pronounced leukocytosis and thrombocytosis. Cytogenetic analysis shows a BCR-ABL fusion gene. A drug with which of the following mechanisms of action is most appropriate for this patient?
(a) Tyrosine kinase inhibitor.
(b) Monoclonal anti-EGFR antibody.
(c) Topoisomerase II inhibitor.
(d) Monoclonal anti-CD20 antibody.
(e) Monoclonal anti-ERBB2 antibody.
(f) Ribonucleotide reductase inhibitor.
(a) Tyrosine kinase inhibitor.
Chronic myeloid leukemia.
Imatinib, nilotinib, dasatinib.
A 9-year-old boy is brought to the emergency department by his mother because of painful swelling in his right knee that started after he collided with another player during a soccer game. He has no history of serious illness except for an episode of prolonged bleeding following a tooth extraction a few months ago. Physical examination shows marked tenderness and swelling of the right knee joint. There are multiple bruises on the lower extremities in various stages of healing. Laboratory studies show a platelet count of 235,000/mm3, partial thromboplastin time of 78 seconds (high), prothrombin time of 14 seconds, and bleeding time of 4 minutes (N = 2–7). Which of the following steps in coagulation is most likely directly affected by this patient's condition?
(a) Formation of thrombin.
(b) Degradation of fibrin.
(c) Conversion of factor X.
(d) Production of vWB factor.
(e) Activation of factor VII.
(C). Conversion of factor X.
Both the intrinsic and extrinsic pathways activate factor X.
Three days after starting a new drug for malaria prophylaxis, a 19-year-old college student comes to the physician because of dark-colored urine and fatigue. He has not had any fever, dysuria, or abdominal pain. He has no history of serious illness. Physical examination shows scleral icterus. Laboratory studies show a hemoglobin of 9.7 g/dL and serum lactate dehydrogenase of 284 U/L. Peripheral blood smear shows poikilocytes with bite-shaped irregularities. Which of the following drugs has the patient most likely been taking?
(a) Pyrimethamine.
(b) Atovaquone.
(c) Primaquine.
(d) Dapsone.
(e) Ivermectin.
(f) Doxycycline.
(g) Mebendazole.
(c) Primaquine.
Glucose-6-phosphate (G6PD) deficiency.
Other drugs: Antimalarials, sulfa drugs, fava beans.
A 2-year-old boy is brought to the physician by his parents for the evaluation of fatigue for several months. The parents report that their son is not as active as he used to be. He was born at 38 weeks' gestation via vaginal delivery. He was breastfed until he was 14 months old. He currently eats some table foods and drinks 27 ounces (800mL) of cow's milk daily. Examination shows mild conjunctival pallor. Examination shows redness and fissures of bilateral corners of the mouth. The remainder of the examination shows no abnormalities. Laboratory studies are most likely to show which of the following?
(a) Mean corpuscular volume?
(b) RBC distribution width?
(c) TIBC?
(d) Serum ferritin?
IDA.
MCV decreased.
RDW increased.
TIBC increased.
Ferritin decreased.
A 25-year-old woman comes to the physician because of recurrent episodes of reddish discoloration of her urine. She also has a 3-month history of intermittent abdominal pain, yellowish discoloration of the skin and eyes, and fatigue. Physical examination shows pallor and scleral icterus. The spleen is not palpable. Her hemoglobin concentration is 7.8 g/dL, leukocyte count is 2,000/mm3, and platelet count is 80,000/mm3. Serum LDH and unconjugated bilirubin concentrations are elevated. Addition of a serum containing anti-human globulins to a blood sample shows no agglutination. A urine dipstick shows blood; urinalysis shows no RBCs. A CT scan of the abdomen shows a thrombus in a distal branch of the superior mesenteric vein. Which of the following is the most likely cause of this patient's condition?
(a) Activation and consumption of platelets and coagulation factors.
(b) Endothelial cell dysfunction from bacterial toxin production.
(c) Absence of protective factors against complement-mediated destruction.
(d) Formation of IgG antibodies against glycoprotein IIb/IIIa.
(e) Replacement of a single amino acid in a beta-globin chain.
(c) Absence of protective factors against complement-mediated destruction.
Paroxysmal nocturnal hemoglobinuria (PNH). Lack of CD55 and CD59 protect RBCs from complement-mediated destruction. Leads to intravascular hemolysis (elevated unconj bilirubin), pancytopenia (same mechanism), venous thrombosis (typically in "atypical" locations).
A 47-year-old woman comes to the physician because of easy bruising and fatigue. She appears pale. Her temperature is 38°C (100.4°F). Examination shows a palm-sized hematoma on her left leg. Abdominal examination shows an enlarged liver and spleen. Her hemoglobin concentration is 9.5 g/dL, leukocyte count is 12,300/mm3, platelet count is 55,000/mm3, and fibrinogen concentration is 120 mg/dL (N = 150–400). Cytogenetic analysis of leukocytes shows a reciprocal translocation of chromosomes 15 and 17. Which of the following is the most appropriate treatment for this patient at this time?
(a) Platelet transfusion.
(b) Rituximab.
(c) All-trans retinoic acid.
(d) Imatinib.
(e) Cyclophosphamide.
(c) ATRA.
Acute promyelocytic leukemia.
An investigator is studying the role of different factors in inflammation and hemostasis. Alpha-granules from activated platelets are isolated and applied to a medium containing inactive platelets. When ristocetin is applied, the granules bind to GpIb receptors, inducing a conformational change in the platelets. Binding of the active component of these granules to GpIb receptors is most likely responsible for which of the following steps of hemostasis?
(a) Platelet adhesion.
(b) Platelet aggregation.
(c) Local vasoconstriction.
(d) Clotting factor activation.
(e) Platelet activation.
(a) Platelet adhesion.
Adhesion = When there is endothelial injury, serum vWF binds to underlying/exposed collagen with its Gp1b receptor, which tethers platelets to the collagen.
A 9-year-old boy is brought to the physician by his parents because of right-sided shoulder pain for 1 day. He has not had chills or sweating. At the age of 3 and 4, he was treated twice in the emergency department for painful swelling of his hands and feet. He emigrated with his family from Kenya 2 years ago. His temperature is 37.4°C (99.3°F), pulse is 96/min, and blood pressure is 123/82 mm Hg. Physical examination shows no tenderness, erythema, or joint swelling of the shoulder. Laboratory studies show:
Hemoglobin 7 g/dL (low)A peripheral blood smear is most likely to show which of the following abnormalities?
(a) Ring-shaped inclusions in erythrocytes
(b) Teardrop-shaped erythrocytes
(c) Nuclear remnants in erythrocytes
(e) Fragmentation of erythrocytes
(c) Nuclear remnants in erythrocytes.
Sickle cell disease, multiple prior pain crises, functional asplenia, no removal of Howell-Jolly bodies.
A 4-year-old boy is brought to the physician by his mother because of generalized weakness and difficulty walking for the past month. Laboratory studies show a hemoglobin concentration of 6.6 g/dL, mean corpuscular volume of 70 μm3, platelet count of 150,000/mm3, and serum total bilirubin concentration of 2 mg/dl. An MRI of the spine shows low signal intensity in all vertebral bodies and a small epidural mass compressing the spinal canal at the level of L1. A CT scan of the head shows osteopenia with widening of the diploic spaces in the skull. A biopsy of the epidural mass shows erythroid colonies with an abundance of megakaryocytes and myeloid cells. Which of the following is the most likely diagnosis?
(a) Hereditary spherocytosis
(b) G6PD deficiency
(c) Aplastic anemia
(d) Lead poisoning
(e) Multiple myeloma
(f) Beta-thalassemia
(f) Beta-thalassemia.
Impaired hematopoiesis, extramedullary hematopoiesis (paravertebral, pathological), microcytic anemia.
A 49-year-old woman is brought to the emergency department by her daughter because of increasing arthralgia, headache, and somnolence for the past week. She has a history of systemic lupus erythematosus without vital organ involvement. She last received low-dose glucocorticoids 2 months ago. Her temperature is 38.6°C (101.5°F), pulse is 80/min, respirations are 21/min, and blood pressure is 129/80 mm Hg. She is confused and disoriented. Examination shows scleral icterus and ecchymoses over the trunk and legs. Neurological examination is otherwise within normal limits. Laboratory studies show:
Hemoglobin 8.7 g/dL
Leukocyte count 6200/mm3
Platelet count 25,000/mm3
Prothrombin time 15 seconds
Partial thromboplastin time 39 seconds
Fibrin split products negative
Serum Bilirubin:
- Total 4.9 mg/dL
- Direct 0.5 mg/dL
A blood smear shows numerous fragmented red blood cells. Urinalysis shows hematuria and proteinuria. Which of the following is the most likely diagnosis?
(a) Immune thrombocytopenic purpura.
(b) Disseminated intravascular coagulation.
(c) Hemolytic uremic syndrome.
(d) Thrombotic thrombocytopenic purpura.
(e) Bernard-Soulier syndrome.
(f) Glanzmann thrombasthenia.
(d) TTP.
Pentad:
(1) Microangiopathic hemolytic anemia (indirect hyperbilirubinemia), (2) thrombocytopenia, (3) renal failure, (4) fever, (5) neurologic changes.
HUS: Renal > neurological, bloody diarrhea (Shiga-toxin).
DIC: Normal coagulation profile.
A 68-year-old man with type 2 diabetes mellitus comes to the physician because of a 5-month history of episodic palpitations, dizziness, and fatigue. His pulse is 134/min and irregularly irregular, and his blood pressure is 165/92 mm Hg. An ECG shows a narrow complex tachycardia with absent P waves. He is prescribed a drug that decreases the long-term risk of thromboembolic complications by inhibiting the extrinsic pathway of the coagulation cascade. The expected beneficial effect of this drug is most likely due to which of the following actions?
(a) Inhibit absorption of vitamin K.
(b) Activate gamma-glutamyl carboxylase.
(c) Activate factor VII calcium-binding sites.
(d) Inhibit reduction of vitamin K.
(e) Inhibit phosphorylation of glutamate on the factor II precursor.
(f) Activate vitamin K epoxide reductase.
(d) Inhibit reduction of vitamin K.
INHIBITS vitamin K epoxide reductase.
Warfarin.
An 11-year-old boy is brought to the physician by his mother because of worsening fatigue. His mother reports that he seems to have trouble keeping up with his older brothers when playing outside. Physical examination shows conjunctival pallor. A hemoglobin electrophoresis is performed. This patient's results are shown in comparison to those of a patient with known sickle cell anemia and a child with normal hemoglobin. Based on this electrophoresis, which of the following types of hemoglobin are dominant in this patient's blood?

(a) HbC only.
(b) HbA, HbC.
(c) HbA, HbS.
(d) HbS only.
(e) HbA, HbF.
(f) HbA only.
(g) HbS, HbC.
(g) HbS, HbC.
HbSC disease, milder sx than those with homozygous sickle cell HbS.
HbC has has +-charged lysine, so it's further from +-charged anode.
A 75-year-old man comes to the physician because of fatigue and decreased urine output for 1 week. He takes ibuprofen as needed for lower back pain and docusate for constipation. Physical examination shows tenderness to palpation over the lumbar spine. There is pedal edema. Laboratory studies show a hemoglobin concentration of 8.7 g/dL, a serum creatinine concentration of 2.3 mg/dL, and a serum calcium concentration of 12.6 mg/dL. Urine dipstick is negative for blood and protein. Which of the following is the most likely underlying cause of this patient's symptoms?
(a) Antiglomerular basement membrane antibodies.
(b) Immunoglobulin light chains.
(c) Renal deposition of AL amyloid.
(d) Anti-dsDNA proteins.
(e) Hypersensitivity reaction
(b) Immunoglobulin light chains.
A 52-year-old woman comes to the physician because of a 6-month history of generalized fatigue, low-grade fever, and a 10-kg (22-lb) weight loss. Physical examination shows generalized pallor and splenomegaly. Her hemoglobin concentration is 7.5 g/dL and leukocyte count is 41,800/mm3. Leukocyte alkaline phosphatase activity is low. Peripheral blood smear shows basophilia with myelocytes and metamyelocytes. Bone marrow biopsy shows cellular hyperplasia with proliferation of immature granulocytic cells. Which of the following mechanisms is most likely responsible for this patient's condition?
(a) Overexpression of the c-KIT gene.
(b) Cytokine-independent activation of the JAK-STAT pathway.
(c) Loss of function of the APC gene.
(d) Altered expression of the retinoic acid receptor gene.
(e) Unregulated expression of the ABL1 gene.
(e) Unregulated expression of the ABL1 gene.
Chronic myeloid leukemia. Reciprocal translocation of the ABL gene on chromosome 9 with BCR gene on chromosome 22, resulting in a Philadelphia chromosome. Expresses non-receptor tyrosine kinase with increased activity.
A 67-year-old man comes to the physician because of a 2-month history of generalized fatigue. On examination, he appears pale. He also has multiple pinpoint, red, nonblanching spots on his extremities. His spleen is significantly enlarged. Laboratory studies show a hemoglobin concentration of 8.3 g/dL, a leukocyte count of 81,000/mm3, and a platelet count of 35,600/mm3. A peripheral blood smear shows immature cells with large, prominent nucleoli and pink, elongated, needle-shaped cytoplasmic inclusions. Which of the following is the most likely diagnosis?
(a) Myelodysplastic syndrome.
(b) Chronic lymphocytic leukemia.
(c) Acute lymphoblastic leukemia.
(d) Acute myelogenous leukemia.
(e) Chronic myelogenous leukemia.
(f) Hairy cell leukemia.
(d) Acute myelogenous leukemia.
Auer rods. > 20% myeloblasts in the bone marrow. AML-defining genetic abnormalities.
A 36-year-old man comes to the physician because of progressive fatigue and night sweats for 2 months. During this time, he has also had a 10-kg (22-lb) weight loss. Physical examination shows painless swelling of the cervical, axillary, and inguinal lymph nodes. Examination of the abdomen shows hepatosplenomegaly. Histologic examination of a lymph node biopsy specimen shows Reed-Sternberg cells. A diagnosis of Hodgkin lymphoma is made. The patient is started on a chemotherapeutic regimen that includes bleomycin. The mechanism of action of this drug is most similar to that of which of the following?
(a) Ciprofloxacin.
(b) Griseofulvin.
(c) Trimethoprim.
(d) Sulfamethoxazole.
(e) Rifampin.
(f) Metronidazole.
(e) Chloramphenicol.
(f) Metronidazole.
Creates free radicals, promotes breakage of DNA strands. Bactericidal antibiotic.
Bleomycin, doxorubicin, daunorubicin cause DNA strand breaks.